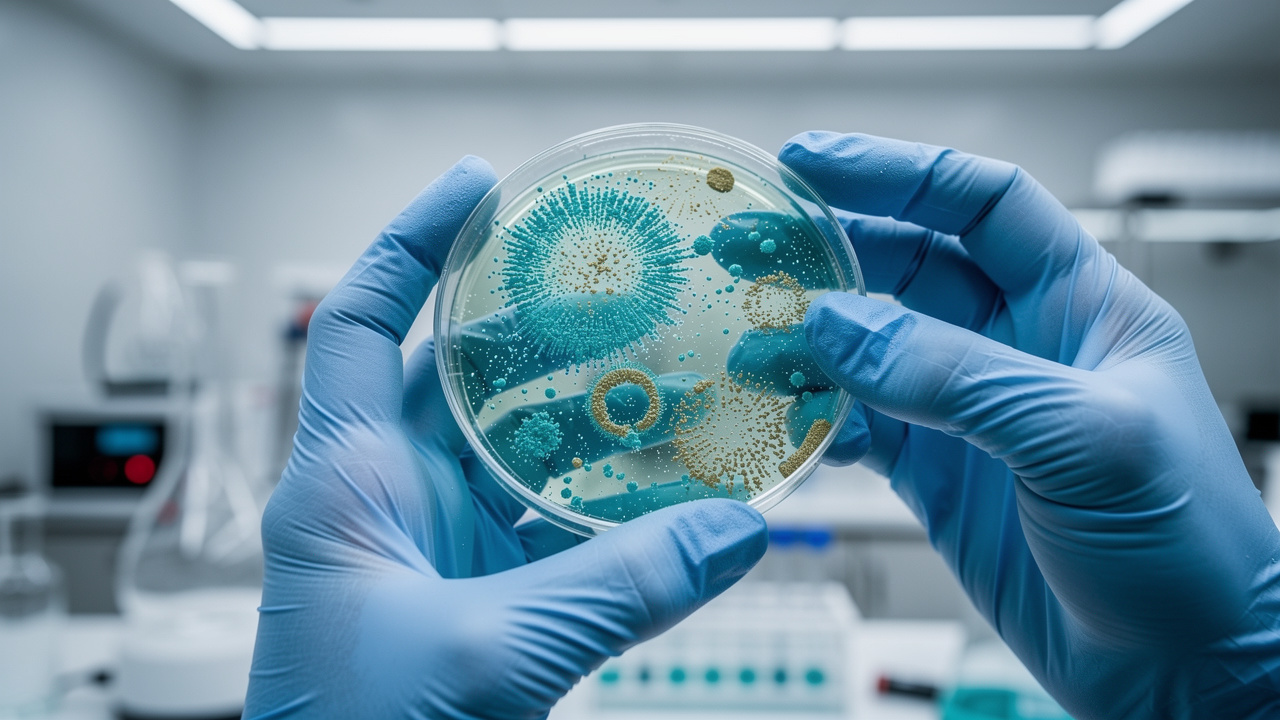
Scientist examining microbial cultures in oncology research laboratory

Introduction
The gut microbiome has become an important part of modern cancer research because it influences far more than digestion alone. This inner ecosystem of bacteria and other microbes helps shape inflammation, immune activity, nutrient processing, and even aspects of treatment response. For people affected by cancer, that makes gut health a meaningful area to understand, not as a source of pressure, but as one more way to support the body with steady, informed care.
The word microbiome refers to the vast community of microorganisms living mainly in the intestines, where they are in constant communication with the immune system. Researchers are increasingly interested in this gut-immune connection because it may affect how the body responds to stress, infection, and cancer therapies. While many questions are still being explored, the overall message is clear: the health of the gut can influence the wider internal environment in ways that matter for wellbeing during and after cancer care.
The gut holds roughly 38 trillion microbial cells, roughly as many microbial cells as human cells in the body. Researchers now take this inner community so seriously that polymorphic microbiomes were added as an emerging theme in the updated Hallmarks of Cancer, the scientific model that explains how cancer develops. These tiny organisms are not bystanders; they are active partners in immunity, inflammation, digestion, and treatment response.
The word microbiome simply describes this whole living community, especially in the intestines. Through the gut-immune axis, gut microbes and immune cells talk with each other constantly, shaping how the body reacts to stress, infection, and cancer therapies. This article from Calming the Mind of Cancer offers a calm overview of what current science suggests, where questions remain, and how to discuss gut health with a trusted care team, so information becomes a source of steadiness rather than pressure.
Key Takeaways
Here are a few grounding ideas before we go deeper.
-
Gut microbes help digest food and regulate inflammation. They send signals that guide immune cells toward or away from action. Because of this, they influence cancer growth, treatment response, and how treatment feels day to day.
-
Studies link richer microbial diversity with better immune balance. Fiber variety, plenty of plant foods, and regular fermented foods are steady helpers. These gentle habits support microbiome and cancer care without harsh rules or rigid diets.
-
Antibiotics, stress, and heavily processed foods can shrink microbial diversity. Probiotics and fecal microbiota transplantation (FMT) show promise but remain specialized tools. Changes in this area belong in talks with clinicians and calm resources from Calming the Mind of Cancer.
What Is The Microbiome — And Why Does It Matter For Cancer?
The word microbiome might sound technical, yet the idea is simple. It means the full community of bacteria, viruses, fungi, and other tiny organisms that live in and on the body. Most of them live in the digestive tract, especially the large intestine, sharing space and constant contact with the food that passes through.
These microbes help with basic tasks every day, such as:
-
Breaking down parts of food the body cannot digest alone, especially many types of fiber
-
Producing vitamins such as some B vitamins and vitamin K
-
Making helpful compounds that feed the cells lining the colon, supporting regular bowel movements and a steadier sense of energy
The gut is also home to a large share of the immune system. Many immune cells sit in or near the intestinal wall, sampling what passes by. Through the gut-immune axis, microbes and immune cells send messages back and forth, teaching the body which signals mean friend and which mean threat, and shaping how strongly inflammation rises in response.
When this community is in balance, it helps keep inflammation in check and protects the thin gut barrier that separates the gut contents from the rest of the body. When that balance is lost — a state called dysbiosis — low grade inflammation can rise and the barrier may become more leaky. Over years, that extra stress may raise the risk of several chronic illnesses, including some cancers. For people interested in microbiome and cancer care, this connection highlights why Calming the Mind of Cancer focuses on gentle nutrition and stress support rather than quick fixes.
An old saying often repeated in medicine is, “All disease begins in the gut.” That is an exaggeration, but modern microbiome research shows why the gut deserves careful attention in cancer care.
How The Gut-Immune Axis Shapes Cancer Development And Progression
As scientists look closer, they see the gut-immune axis touching many steps in how cancer can form and grow, from early DNA damage to the way tumors interact with treatment.
When Microbial Balance Tips: Dysbiosis And Cancer Risk
Dysbiosis is the term for an imbalanced microbiome, when helpful microbes shrink and more troublesome ones gain ground. This shift can raise chronic, low grade inflammation. Over time, steady inflammatory signals create stress inside cells and can dull the immune system’s ability to notice and clear damaged or abnormal cells before they form larger problems.
In this setting, some microbes also make substances that harm DNA or disturb normal cell repair:
-
Certain strains of Escherichia coli produce colibactin, a compound linked to DNA breaks seen in colorectal cancer.
-
Fusobacterium nucleatum, a bacterium that usually lives in the mouth, often shows up inside colon tumors and has been tied to both inflammation and chemotherapy resistance.
Researchers also talk about a tumor microbiome — microbes living inside tumors themselves — yet they stress that dysbiosis is one factor among many, alongside genes, toxins, hormones, and lifestyle. The microbiome does not cause cancer on its own, but it can tilt the scales toward higher or lower risk.
The Protective Side: Microbes That Support Immunity
Many gut microbes work in the opposite direction and quietly protect health. When bacteria ferment dietary fiber, they create short chain fatty acids (SCFAs) such as butyrate that feed colon cells, support the gut barrier, and calm excessive inflammation. In lab studies, butyrate can even trigger gentle programmed death in some cancer cells, which helps explain why fiber is so often linked with lower cancer risk.
Several bacterial groups appear often in this research, including:
-
Akkermansia muciniphila
-
Bifidobacterium species
-
Faecalibacterium prausnitzii
-
Many Lactobacillus strains
Higher levels of these microbes, along with greater microbial diversity overall, are linked with stronger immune responses and better results from some immune‑based drugs. Public voices like Mark Hyman, David Perlmutter, and Zach Bush have drawn attention to the gut‑brain‑immune link, while peer reviewed work from teams such as Routy and Gopalakrishnan shows that supporting the microbiome can matter for treatment response.
One researcher described the microbiome as “a hidden organ that quietly shapes how the immune system behaves.” For cancer patients, that hidden organ can influence both risk and recovery.
The Microbiome And Cancer Treatment: What The Research Shows
These same gut microbes also interact with many cancer treatments in surprising and important ways.
Immunotherapy: The Most Striking Connection
Some of the clearest links between the microbiome and cancer care appear in immunotherapy. Immune checkpoint inhibitors, drugs that target PD‑1 or CTLA‑4, lift the brakes from immune cells so they can attack tumors. Studies in melanoma, lung cancer, and other solid tumors show that people with richer gut microbial diversity — and more microbes such as Akkermansia muciniphila, Bifidobacterium, and Faecalibacterium prausnitzii — tend to respond better.
Several patterns keep showing up in research:
-
People with higher microbial diversity and more SCFA‑producing bacteria often have stronger responses to checkpoint inhibitors.
-
Broad spectrum antibiotics given shortly before or during immunotherapy often flatten microbial diversity, and many studies link this pattern with lower response rates and shorter survival.
-
Early trials report that some people with melanoma who did not respond to immunotherapy began to respond after receiving fecal microbiota transplantation (FMT) from donors who had done well on the same drugs.
These findings do not make antibiotics or FMT good or bad on their own, but they are strong reasons to talk with the oncology team about timing and options. No one should change or delay cancer treatment without careful medical advice, yet asking how gut health fits into the plan is reasonable and increasingly welcomed.
Chemotherapy, Radiotherapy, And Treatment Tolerance
The microbiome also interacts with more familiar treatments. Some chemotherapy drugs, such as cyclophosphamide and oxaliplatin, rely on gut microbes to trigger immune reactions that help the drugs work fully. At the same time, certain bacteria inside pancreatic tumors can change the drug gemcitabine into an inactive form, which may contribute to chemotherapy resistance even when doses are correct. Many classic side effects of chemotherapy, including diarrhea and mouth sores, appear when the gut lining and its microbes are deeply disturbed.
Radiotherapy shows similar links. Pre‑treatment gut patterns can hint at who is more likely to develop radiation‑related bowel problems, and bacteria from the Lachnospiraceae family that make short chain fatty acids may protect some healthy tissue.
The microbiome is not just a bystander during cancer treatment — it is an active co‑participant in how the body responds.
This does not make treatment choices simple, yet it does mean gut health deserves space in talks with clinicians and nutrition professionals.
Supporting Your Microbiome Through Diet And Lifestyle

Amid complex medical decisions, everyday habits still offer a gentle way to support the microbiome and cancer care.
Fiber, Fermented Foods, And Plant Variety

Food is one of the steadiest tools for supporting gut health during cancer treatment. Dietary fiber gives gut microbes their favorite fuel, and different fibers feed different bacterial groups. Studies in people with melanoma link higher fiber intake with better responses to some immunotherapy drugs, likely because fiber leads to more short chain fatty acids and a calmer gut lining. Adding beans or lentils, whole grains, seeds, fruits, and vegetables across the week is a simple way to begin.
You might think about:
-
Fiber‑rich staples: oats, barley, quinoa, brown rice, whole grain breads and crackers
-
Legumes: beans, lentils, chickpeas, split peas
-
Nuts and seeds: almonds, walnuts, chia seeds, flaxseeds
-
Colorful produce: berries, leafy greens, carrots, squash, onions, garlic
Fermented foods add another quiet helper. Yogurt with live cultures, kefir, kimchi, sauerkraut, and miso can increase microbial diversity when they fit with treatment plans. Eating many different plant foods each week, including polyphenol‑rich choices like berries, green tea, dark chocolate, and extra virgin olive oil, also supports a rich gut community and matches the antioxidant‑focused guidance shared by Calming the Mind of Cancer.
A practical rule many dietitians use is, “Aim for 20–30 different plant foods a week, not perfection every day.” Variety over time is what seems to matter most.
What To Approach Mindfully (Without Fear)

Supporting the microbiome is not only about what to add. Diets built mainly from ultra processed foods and added sugars can feed more inflammatory bacteria and starve helpful ones over time. This is not a reason for guilt, but it can guide gentle swaps toward whole, simple foods most of the time.
Antibiotics are another strong influence. They can save lives yet also wipe out large portions of the gut community. When antibiotics are needed during microbiome and cancer care, it is worth asking the team about timing, possible alternatives, and whether probiotic support fits the situation. Research on probiotic supplements is promising but mixed, and there is no single magic formula.
If antibiotics are suggested, questions like these can open a helpful conversation:
-
“Is this the narrowest antibiotic that will still do the job?”
-
“How long do I need to take it?”
-
“Should I separate it from probiotic foods or supplements in time?”
Stress also matters. The gut and brain talk through nerves, hormones, and immune signals, so frequent stress can disturb gut balance. Gentle practices such as breathing exercises, guided imagery, and meditation — like those shared by Calming the Mind of Cancer — can support both mood and microbiome health.
The Future Of Microbiome Research In Cancer Care
Microbiome science is moving quickly, and cancer research sits near the center of that motion. One active area looks at diagnostic tools based on microbial patterns. In colorectal cancer, models that analyze stool for certain bacterial signatures can already tell patients from healthy volunteers with high accuracy in research settings, and saliva‑based tests are being explored for oral, pancreatic, and lung cancers.
Blood‑based liquid biopsies push this idea further. Early studies suggest that combinations of bacterial and fungal fingerprints in blood may help detect many kinds of cancer, sometimes at very early stages. Therapies are also changing, with trials testing:
-
Synbiotics, which mix prebiotics and probiotics
-
Postbiotics, which use inactivated microbes or their helpful parts
Both are being studied to support immunotherapy response and ease treatment‑related bowel problems.
Researchers are even finding that microbes living inside tumors can predict how long some patients live after therapy, raising the chance that microbiome measures will become a standard part of oncology. Other experiments are designing engineered microbes that might one day sense tumor conditions or deliver drugs right where they are needed. Not every idea will reach the clinic, yet the overall trend is hopeful. Calming the Mind of Cancer follows this fast‑moving field and offers clear, compassionate updates so people can talk with their own clinicians from a place of calm knowledge.
The science may be complex, but the message for patients stays simple: care for your gut as well as you reasonably can, and let your medical team handle the rest.
Conclusion
All of this research shows that the microbiome is not a fringe wellness idea. It is a central player in cancer development, treatment response, side effects, and recovery, linked through the gut-immune axis to digestion, inflammation, mood, and many layers of immunity.
The hopeful part is that many supports for this inner community are simple and gentle. Shifts toward more fiber, plant variety, and fermented foods, thoughtful use of antibiotics, and regular stress‑calming practices can all nudge the microbiome in a kinder direction, even during demanding treatment. Calming the Mind of Cancer offers guides on antioxidant‑rich foods, superfoods, and holistic support, so changes can happen one small step at a time. You are not alone in this process, and understanding your body’s systems can give back a sense of steady, quiet agency.
FAQs
What Is The Gut-Immune Axis And Why Does It Matter For Cancer Patients?
Doctors use the phrase gut-immune axis to describe the constant two‑way communication between gut microbes, the intestinal lining, and immune cells. A large share of the body’s immune cells sit in or near the gut. Signals from microbes help train these cells, shape inflammation, and guide how the body responds to infections and abnormal cells, which is why this axis matters for cancer patients.
Can What I Eat Really Affect My Microbiome During Cancer Treatment?
Yes, diet is one of the most steady and well‑studied ways to shape the microbiome, even during treatment. Fiber variety, plenty of plant foods, and regular fermented foods support microbial richness and short chain fatty acid production. At the same time, appetite changes and nausea are real, so working with a dietitian or a resource such as Calming the Mind of Cancer can keep goals gentle and realistic.
Should I Take Probiotics During Cancer Treatment?
Research on specific probiotic strains in cancer care is promising, yet it is not simple. Different strains do very different things, and the right choice, dose, and timing depend on diagnosis, immune status, and medications. For some people with very low white blood cell counts, certain probiotics may be unsafe, so any supplement choice should be reviewed with the oncology or integrative team first.
What Is Fecal Microbiota Transplantation And Is It An Option For Cancer Patients?
Fecal microbiota transplantation (FMT) means transferring stool from a screened donor into the gut of a recipient to reset the microbial community. It is already used for some stubborn gut infections. In oncology research, FMT has helped some people with melanoma who did not respond to immunotherapy begin to respond, but it remains experimental and is usually offered only in clinical trials.
How Does Antibiotic Use Affect Cancer Treatment Outcomes?
Broad spectrum antibiotics can sharply reduce gut microbial diversity. Studies show that when they are given shortly before or during immunotherapy, treatment responses and survival rates often drop. Sometimes antibiotics are essential, and they should never be stopped without medical advice, yet this link is worth discussing with the oncology team when planning care.



